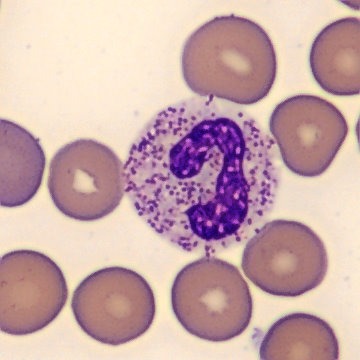
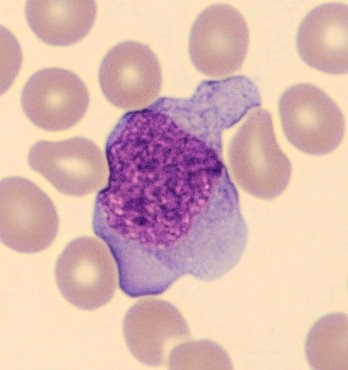

Alterações Laboratoriais nas Infecções Bacterianas e Virais
O hemograma constitui um dos exames laboratoriais mais solicitados na prática clínica e, portanto, é fundamental tanto para o diagnóstico quanto para o acompanhamento da evolução e da resposta terapêutica em diferentes condições infecciosas. A partir da avaliação quantitativa e qualitativa das séries eritrocitária, leucocitária e plaquetária, esse exame passa a fornecer informações essenciais sobre a resposta do organismo frente às infecções. Dessa forma, torna-se possível a identificação de padrões inflamatórios, alterações imunológicas e, além disso, a detecção de possíveis complicações associadas.
Nesse contexto, as infecções virais e bacterianas cursam com alterações hematológicas distintas, que auxiliam na diferenciação etiológica, na avaliação da gravidade do quadro e no direcionamento das condutas clínicas. Sendo assim, a correta interpretação do hemograma, aliada ao conhecimento dos mecanismos fisiopatológicos envolvidos, torna-se indispensável para o profissional da área da saúde, especialmente no cotidiano laboratorial, contribuindo para uma abordagem diagnóstica mais segura, eficaz e baseada em evidências.
Principais alterações hematológicas em infecções bacterianas
Durante infecções bacterianas, o hemograma apresenta alterações características que, de modo geral, refletem a intensa resposta do sistema imunológico. Nesse cenário, essas mudanças indicam a presença de inflamação ativa e, além disso, auxiliam no monitoramento da gravidade da infecção.
- Leucocitose: aumento do número total de leucócitos no sangue.
- Predomínio de neutrófilos segmentados na contagem diferencial.
- Desvio à esquerda: presença de formas imaturas de neutrófilos, como bastonetes, metamielócitos e mielócitos.
- Granulações tóxicas nos neutrófilos.
- Corpúsculos de Döhle e vacúolos citoplasmáticos.
- Alterações plaquetárias: agregados plaquetários e variações na contagem.
- Alterações morfológicas nas hemácias: células gigantes, esquizócitos e acantócitos, especialmente em casos graves como sepse.
Principais alterações hematológicas em infecções virais
As infecções virais provocam alterações específicas no hemograma que, de maneira geral, refletem a resposta imunológica do organismo. Portanto, entre os achados mais frequentes, destacam-se a leucopenia, causada pela redução da produção ou pelo aumento da destruição de leucócitos, e, em paralelo, a linfocitose, resultante da ativação e proliferação de linfócitos com o objetivo de combater o vírus.
Além disso, em alguns casos, podem ser observados linfócitos reativos, os quais se caracterizam por aumento do tamanho celular, presença de núcleo imaturo e citoplasma intensamente basofílico. No que se refere à série plaquetária, alterações também podem ocorrer, levando à plaquetopenia, seja por supressão medular, seja pelo consumo aumentado durante a resposta inflamatória.
- Leucopenia: redução do número total de leucócitos.
- Linfocitose: aumento da quantidade de linfócitos maduros circulantes.
- Linfócitos reativos: células aumentadas, núcleo imaturo, citoplasma basofílico intenso.
- Plaquetopenia: diminuição do número de plaquetas devido à supressão medular ou consumo aumentado.
- Alterações morfológicas em hemácias: menos frequentes, mas podem ocorrer dependendo do vírus.
Conclusão
Sendo assim, a interpretação combinada de parâmetros clássicos, alterações morfológicas e índices derivados, como NLR, PLR e NLPR, amplia a capacidade diagnóstica e prognóstica do exame. Dessa forma, o monitoramento hematológico fornece informações valiosas para orientar condutas clínicas, identificar complicações precoces e diferenciar tipos de infecções, reforçando seu papel central na prática laboratorial e na gestão de pacientes infectados.
O próximo passo de todo analista que deseja ter mais segurança na bancada
Todo analista que busca se destacar e se tornar um profissional mais atualizado, capacitado e qualificado para o mercado de trabalho precisa considerar uma pós-graduação.
Um profissional com especialização é valorizado na área laboratorial; esse é um fato inegável.
Unimos o útil ao agradável ao desenvolver uma pós-graduação em Hematologia Laboratorial e Clínica.
Para aqueles que procuram a comodidade de uma pós-graduação 100% online e ao vivo, sem abrir mão da excelência no ensino, temos a solução ideal.
Nossa metodologia combina teoria e prática da rotina laboratorial, garantindo um aprendizado efetivo.
Contamos com um corpo docente altamente qualificado, com os melhores professores do Brasil, referências em suas áreas de atuação.
No Instituto Nacional de Medicina Laboratorial, temos apenas um objetivo: mais do que ensinar, vamos tornar VOCÊ uma referência.
Toque no botão abaixo e conheça a pós-graduação em Hematologia Laboratorial e Clínica.
QUERO CONHECER TODOS OS DETALHES DA PÓS-GRADUAÇÃO
Referências:
SILVA ARAÚJO, Fernanda Martins da. Alterações no hemograma nas infecções virais e bacterianas: uma revisão de literatura. 2023. Trabalho de Conclusão de Curso (Graduação em Biomedicina) – Centro de Biociências, Universidade Federal do Rio Grande do Norte, Natal, 2023.
OLIVEIRA COSTA, L. G. de; LAURINDO DA SILVA, V. F.; DA SILVA OLIVEIRA, C. S.; BERNARDES, G. P.; REZENDE E ALMEIDA, B. V.; RESENDE BORGES, K. D. O.; RESENDE E ALMEIDA, G. M. O papel do hemograma no diagnóstico e manejo de infecções virais: uma revisão sistemática. Hematologia, Transfusão e Terapia Celular, v. 47, suplemento 3, p. 104236, out. 2025.



